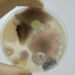
Accuracy Matters: Evaluating the Effectiveness of DIY Mold Tests Against Professional Standards

Detoxifying Your Life: Strategies to Counteract Mold’s Neurological Effects

Mold is a type of fungus that can grow in damp environments and can cause a range of health problems. Exposure to toxic mold can have serious neurological consequences, affecting the brain and nervous system. Mycotoxins, the toxic substances produced by some types of mold, can cause a variety of symptoms, including fatigue, headaches, memory loss, and mood changes.
Understanding the impact of mold on health is crucial for identifying and addressing mold-related conditions. Identifying mold in your environment and taking steps to reduce exposure can help prevent the development of mold-related health problems. Strategies for reducing mold exposure include maintaining a dry and well-ventilated home, using air purifiers, and avoiding damp areas.
Dietary and lifestyle adjustments, such as incorporating antioxidant-rich foods and supplements, can also support the body’s natural detoxification processes. Medical and therapeutic interventions, such as detoxification protocols and neurofeedback therapy, may be necessary for those with severe mold-related conditions. By monitoring and managing mold-related conditions, individuals can take control of their health and reduce the impact of mold on their neurological function.
Key Takeaways
- Mold exposure can have serious neurological consequences, affecting the brain and nervous system.
- Identifying mold in your environment and taking steps to reduce exposure can help prevent the development of mold-related health problems.
- Dietary and lifestyle adjustments, medical interventions, and monitoring and managing mold-related conditions can support the body’s natural detoxification processes and reduce the impact of mold on neurological function.
Understanding Mold and Its Impact on Health
Mold is a type of fungus that can grow indoors and outdoors in warm, damp environments. There are many different types of mold, each with its own distinct characteristics and associated health risks. Some of the most common types of mold include Aspergillus, Penicillium, Cladosporium, and Stachybotrys.
Types of Mold and Associated Toxins
Stachybotrys, commonly known as black mold, is one of the most toxic types of mold. It produces mycotoxins that can cause a range of health problems, including neurological symptoms such as headaches, memory loss, and confusion. Other types of mold, such as Aspergillus and Penicillium, can also produce mycotoxins that can cause health problems.
Common Health Effects of Mold Exposure
Exposure to mold can cause a range of health problems, depending on the type of mold, the level of exposure, and the individual’s sensitivity. Some common health effects of mold exposure include:
- Allergic reactions: Exposure to mold can cause allergic reactions in some people, including sneezing, runny nose, itchy eyes, and skin rash.
- Respiratory problems: Mold spores can irritate the respiratory system and cause coughing, wheezing, and shortness of breath.
- neurological symptoms: Some types of mold can produce mycotoxins that can cause neurological symptoms such as headaches, memory loss, and confusion.
- Toxicity: Exposure to high levels of mold can cause toxicity, which can lead to a range of health problems, including liver and kidney damage.
It is important to note that not everyone who is exposed to mold will experience health problems. However, individuals who are sensitive to mold or have pre-existing health conditions may be more susceptible to the health effects of mold exposure.
In the next section, we will discuss strategies for detoxifying your life and counteracting the neurological effects of mold.
Neurological Consequences of Mold Exposure
Mold exposure can have serious neurological consequences on the human brain. Mold inhalation can cause innate immune activation, neural, cognitive, and emotional dysfunction, as documented by a variety of studies [1][2][3].
Cognitive Impairment and Memory Loss
Mold exposure can lead to cognitive impairment and memory loss. Studies have shown that mold exposure can cause damage to the hippocampus, the region of the brain responsible for memory and learning [1][4]. Mold exposure can also cause neurodegenerative diseases such as Alzheimer’s and Parkinson’s [5].
Mood Disorders and Neurological Symptoms
Mold exposure can lead to mood disorders and other neurological symptoms such as autism, psychosis, and traumatic brain injury [1][2][3]. Neuroinflammation, caused by mold exposure, can lead to depression, anxiety, and other mood disorders [6].
To counteract the neurological effects of mold exposure, it is important to take preventative measures such as keeping indoor humidity levels below 50%, fixing any leaks or water damage immediately, and ensuring proper ventilation in damp areas such as bathrooms and kitchens. In addition, air purifiers and HEPA filters can be used to remove mold spores from the air [2].
It is important to seek medical attention if you suspect mold exposure and are experiencing any neurological symptoms. A healthcare professional can provide guidance on the appropriate course of treatment.
Overall, mold exposure can have serious neurological consequences and it is important to take preventative measures to avoid exposure.
Identifying Mold in Your Environment

Mold is a common problem that can cause a variety of health issues, including neurological effects. To counteract mold’s neurological effects, it is important to identify mold in your environment. This section will discuss the sources of indoor mold and the signs of mold growth.
Sources of Indoor Mold
Indoor mold can grow on any surface that is wet or damp. Mold spores are present everywhere in the environment, but they can only grow when they have a source of moisture. Some common sources of moisture that can lead to indoor mold growth include:
- Water damage from leaking pipes, roofs, or windows
- High humidity levels
- Poor ventilation
- Condensation on windows or walls
Indoor mold can also grow in moldy buildings, such as those with water damage or poor ventilation. If you suspect that your building has mold, it is important to have it inspected and remediated by a professional.
Signs of Mold Growth
If you suspect that there is mold in your environment, it is important to look for signs of mold growth. Some common signs of mold growth include:
- Visible mold growth on walls, ceilings, or floors
- A musty or moldy odor
- Water stains on walls or ceilings
- Peeling or bubbling paint or wallpaper
- Allergic reactions, such as sneezing, coughing, or itchy eyes
If you notice any of these signs, it is important to have your environment inspected for mold. Regular inspections and maintenance can help prevent mold growth and counteract its neurological effects.
Strategies for Reducing Mold Exposure
Mold exposure can cause a wide range of health issues, including neurological effects. Therefore, it is essential to take measures to reduce exposure to mold. Here are some strategies that can help:
Mold Remediation Techniques
The first step in reducing mold exposure is to remove any existing mold from your surroundings. Mold removal can be a challenging task, and it is best to hire a professional mold remediation company. They have the expertise and equipment to remove mold safely and effectively.
If you want to tackle mold removal yourself, you can use a variety of techniques. For example, you can use bleach, vinegar, or hydrogen peroxide to kill mold. However, it is essential to use protective gear such as gloves, goggles, and a mask when working with mold.
Preventing Mold Growth
Preventing mold growth is another crucial step in reducing mold exposure. Here are some strategies that can help:
-
Keep your home dry: Mold thrives in moist environments, so it is essential to keep your home dry. Use dehumidifiers to reduce humidity levels, especially in areas such as basements and bathrooms.
-
Fix leaks: Leaks can cause moisture buildup, which can lead to mold growth. Therefore, it is essential to fix any leaks in your home promptly.
-
Control mice: Mice can bring mold spores into your home, which can lead to mold growth. Therefore, it is essential to control mice by sealing any gaps or holes in your home’s exterior and keeping your home clean.
In conclusion, reducing mold exposure is crucial for maintaining good health, especially neurological health. By using the strategies mentioned above, you can reduce mold exposure and keep yourself and your family healthy.
Dietary and Lifestyle Adjustments

When it comes to detoxifying the body from mold toxicity, dietary and lifestyle adjustments are crucial. The following subsections will discuss some of the dietary and lifestyle changes that can help counteract mold’s neurological effects.
Anti-Inflammatory Foods
Inflammation is a natural response of the immune system to injury and infection. However, chronic inflammation can lead to a host of health problems, including neurological issues. Incorporating anti-inflammatory foods into the diet can help reduce inflammation in the body. Some of the best anti-inflammatory foods include:
- Fatty fish, such as salmon and sardines
- Berries, such as blueberries and strawberries
- Leafy greens, such as spinach and kale
- Nuts, such as almonds and walnuts
- Turmeric, which contains the anti-inflammatory compound curcumin
Supplements and Detoxification
Supplements can also be beneficial when it comes to detoxifying the body from mold toxicity. Some of the best supplements for detoxification include:
- Activated charcoal, which can bind to toxins and help remove them from the body
- Probiotics, which can help support gut health and boost the immune system
- Milk thistle, which can help support liver function, a key organ in detoxification
In addition to supplements, lifestyle adjustments can also aid in detoxification. These adjustments include:
- Sweating, which can help remove toxins from the body
- Getting enough sleep, which is crucial for overall health and detoxification
- Reducing stress, which can help boost the immune system and aid in detoxification
Finally, incorporating enzymes into the diet can also be beneficial. Enzymes are essential for digestion and can help break down toxins in the body. Some of the best enzyme-rich foods include:
- Pineapple, which contains the enzyme bromelain
- Papaya, which contains the enzyme papain
- Kiwi, which contains the enzyme actinidin
By incorporating these dietary and lifestyle adjustments, individuals can help counteract mold’s neurological effects and support overall health and well-being.
Medical and Therapeutic Interventions

Medications and Treatments
Medications and treatments can be used to address the symptoms of mold exposure and detoxify the body. Healthcare professionals may prescribe medications to alleviate symptoms such as headaches, fatigue, and respiratory issues. Antifungal medications may also be prescribed to treat fungal infections caused by mold exposure.
In addition, intravenous (IV) therapy can be used to administer high doses of vitamins, minerals, and antioxidants to support the body’s natural detoxification process. IV therapy can also be used to address nutrient deficiencies caused by mold exposure.
Functional Medicine Approaches
Functional medicine approaches can be used to address the root cause of mold exposure and promote overall health and wellness. Functional medicine practitioners may use a variety of diagnostic tests to identify underlying health issues and nutrient deficiencies.
Once identified, functional medicine practitioners may recommend dietary changes, supplements, and lifestyle modifications to support the body’s natural detoxification process. They may also recommend therapies such as sauna therapy, colon hydrotherapy, and lymphatic drainage to help the body eliminate toxins.
It is important to consult with a healthcare professional before starting any medications or treatments for mold exposure. It is also important to work with a qualified functional medicine practitioner who can provide personalized recommendations based on individual health needs.
Monitoring and Managing Mold-Related Conditions
Mold exposure can lead to various health conditions, including asthma, infections, chronic fatigue, allergies, respiratory conditions, mold illness, chronic health problems, and compromised immune systems. It is essential to monitor and manage these conditions to prevent long-term health effects.
Recognizing Persistent Symptoms
Individuals who are exposed to mold may experience persistent symptoms that can significantly affect their quality of life. These symptoms include:
- Nasal congestion or runny nose
- Coughing or wheezing
- Sore throat
- Skin irritation or rash
- Headaches
- Fatigue or weakness
- Difficulty concentrating or remembering
- Mood swings or depression
If an individual experiences persistent symptoms, they should seek medical attention. A healthcare provider can evaluate the symptoms and determine if they are related to mold exposure. They may recommend various treatments, such as medication or allergy shots, to manage the symptoms.
Long-Term Health Management
Long-term health management is crucial for individuals who have been exposed to mold. They should take steps to minimize their exposure to mold and manage any related health conditions. Here are some strategies that can help:
- Keep indoor humidity levels below 50% to prevent mold growth.
- Fix any leaks or water damage promptly.
- Use an air purifier with a HEPA filter to remove mold spores from the air.
- Clean moldy surfaces with a solution of bleach and water.
- Wear protective gear, such as gloves and a mask, when cleaning moldy areas.
- Take allergy medication or use a nasal spray to manage allergy symptoms.
- Practice good hygiene, such as washing hands frequently and avoiding touching the face.
- Eat a healthy diet and get regular exercise to support overall health.
Individuals with compromised immune systems or chronic health problems may require additional medical care. They should consult with their healthcare provider to develop a long-term management plan that addresses their specific needs.
In conclusion, monitoring and managing mold-related conditions is essential for preventing long-term health effects. By recognizing persistent symptoms and implementing strategies to minimize exposure to mold, individuals can improve their quality of life and support their overall health.
Conclusion
Detoxifying your life from mold exposure is an ongoing process that requires continuous vigilance. However, with the right knowledge and strategies, it is possible to overcome the neurological effects of mold exposure with confidence.
By incorporating a healthy diet rich in leafy greens, garlic, ginger, and turmeric, individuals can support mold detoxification. Supplements such as activated charcoal, probiotics, and milk thistle can also aid this process and support liver function, a key organ in detoxification [1].
It is important to remain vigilant and proactive in identifying and addressing mold exposure in the home or workplace. Regularly inspecting for water damage, promptly addressing leaks, and ensuring proper ventilation can help prevent mold growth.
Empowerment through knowledge is also crucial in overcoming mold exposure. Understanding the potential impact on health and wellness can motivate individuals to take the necessary steps to reduce exposure, remediate mold-infested environments, and support their overall well-being [2].
Overall, by being proactive and informed, individuals can confidently counteract the neurological effects of mold exposure and live a healthy, mold-free life.
[1] Source: How To Detox Your Body From Mold Toxicity – planetnaturopath.com
[2] Source: The Neurological Effects of Mycotoxins from Mold Exposure – austinmdclinic.com
Frequently Asked Questions
What are effective dietary strategies to eliminate mold from the body?
Dietary strategies can play a crucial role in eliminating mold from the body. Some effective dietary strategies include consuming foods that are low in sugar, high in fiber, and rich in antioxidants. Antioxidant-rich foods such as berries, dark chocolate, and leafy greens can help neutralize the harmful effects of mold toxins in the body. Additionally, consuming probiotic-rich foods such as yogurt and kefir can help improve gut health and support the body’s natural detoxification processes.
What natural remedies can assist in detoxifying the body from mold exposure?
Several natural remedies can assist in detoxifying the body from mold exposure. Activated charcoal, bentonite clay, and chlorella are natural remedies that can help bind to mold toxins and eliminate them from the body. Additionally, herbs such as milk thistle and dandelion root can support liver function and aid in the removal of toxins from the body.
What are common symptoms to expect during mold detoxification?
During mold detoxification, some common symptoms that individuals may experience include headaches, fatigue, muscle aches, and digestive issues. These symptoms occur as the body works to eliminate mold toxins from the body. It is important to note that everyone’s experience with mold detoxification can differ, and individuals should consult with a healthcare provider if they experience severe symptoms.
Which supplements are recommended for aiding in the removal of mold from the body?
Several supplements can aid in the removal of mold from the body. Vitamin C, magnesium, and zinc are essential nutrients that can support the body’s natural detoxification processes. Additionally, supplements such as N-acetylcysteine (NAC) and glutathione can help support liver function and aid in the removal of toxins from the body.
What methods can help in detoxifying mold from the neurological system?
Detoxifying mold from the neurological system can be challenging. However, some effective methods include using infrared saunas, taking Epsom salt baths, and practicing yoga. Infrared saunas can help eliminate toxins from the body through sweating, while Epsom salt baths can help relax the muscles and aid in the removal of toxins. Additionally, yoga can help reduce stress and improve circulation, which can aid in the body’s natural detoxification processes.
Can the effects of mold toxicity be reversed, and if so, how?
The effects of mold toxicity can be reversed with proper treatment and support. Treatment may include detoxification protocols, dietary changes, and lifestyle modifications. Additionally, working with a healthcare provider who specializes in mold toxicity can help individuals develop a personalized treatment plan to address their specific needs. It is important to note that the length of time it takes to reverse the effects of mold toxicity can vary depending on the severity of the exposure and the individual’s overall health.